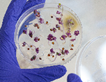
inoculum

Located in a vast number of major agricultural regions, our field staff can collect pest colonies, weed seeds and disease strains for sensitivity testing at your own facility or at one of our laboratories.
Our expert teams can establish sensitivity to your products using standard methods or developing a suitable methodology where necessary, for post-registration monitoring or to study the baseline of sensitivity for new active substance.
All monitoring campaigns are carefully planned and we provide scientific guidance about sampling methods and representative areas for each crop and target, to optimize the number and geographical spread of sites.